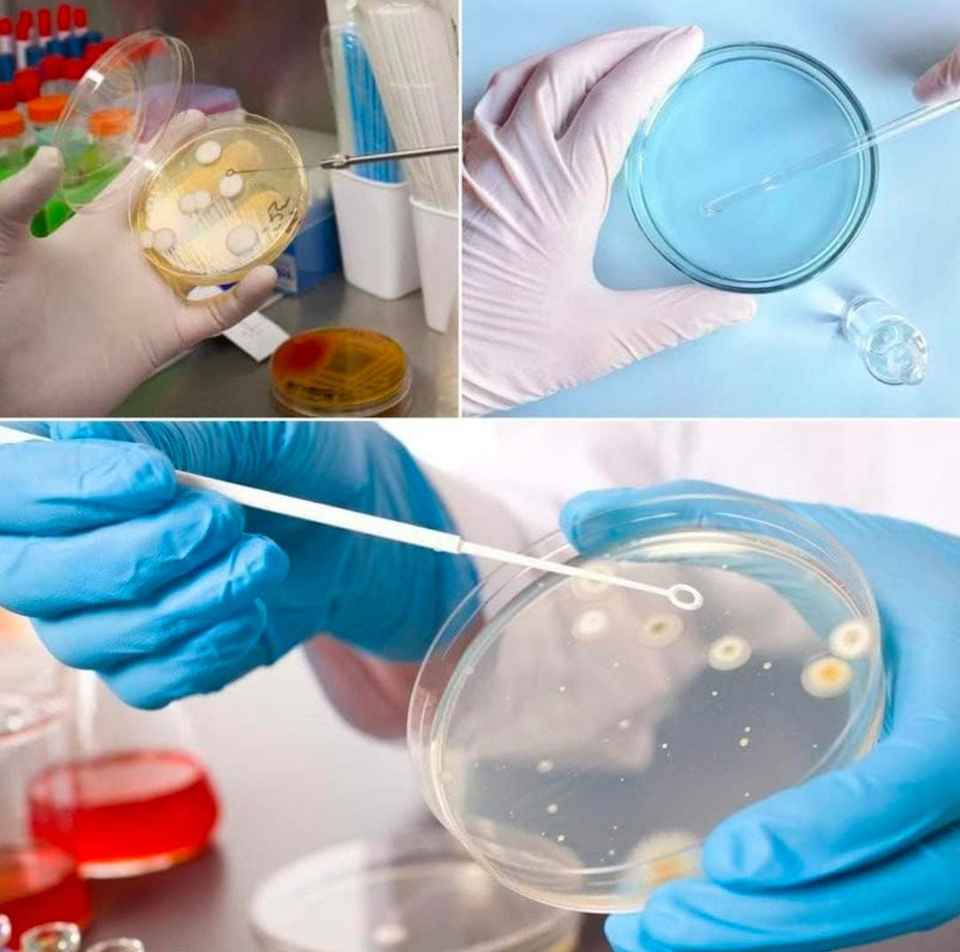
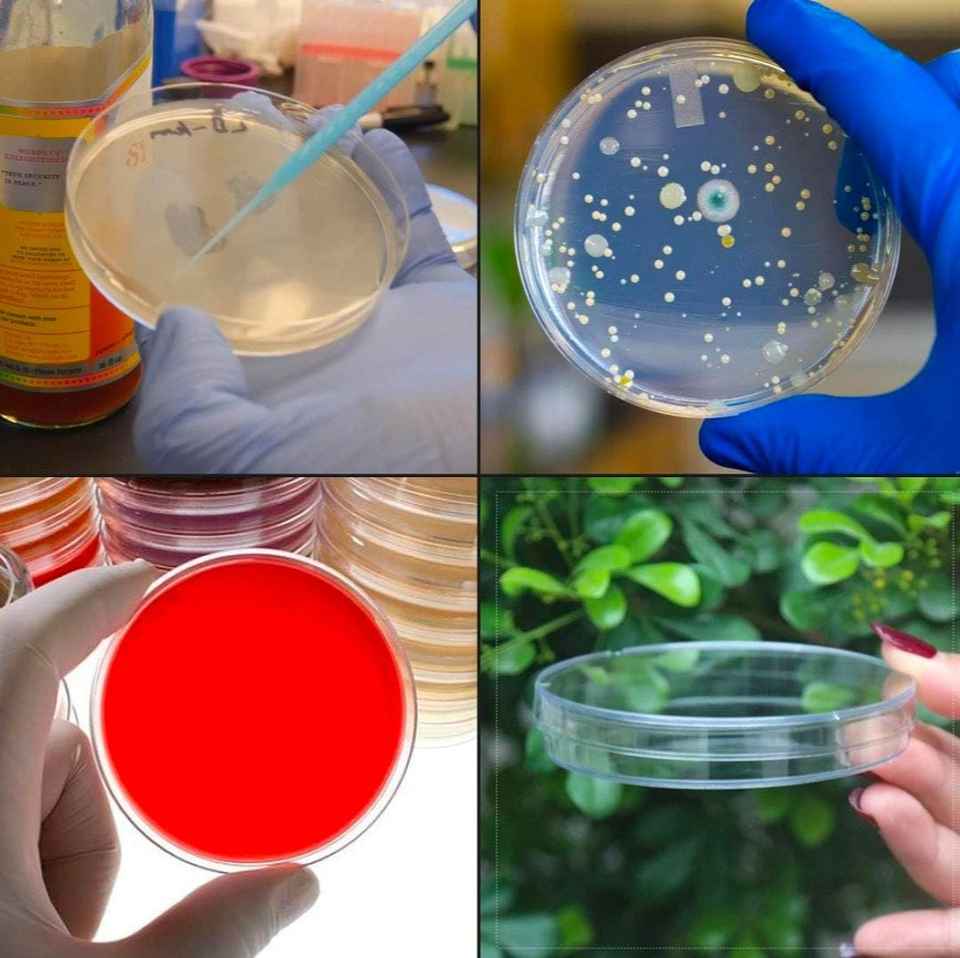

Boîtes de Pétri stériles jetables en plastique transparent Eleos Care 90x15mm avec 2 compartiments, tailles 60mm/35mm/150mm, garantie 3 ans
Aucun avis pour l'instant


THAKUR ENTERPRISE
KOLKATA, IN3 ans sur Alibaba.comFournisseur polyvalent
3.2/5.0(7 commentaires)Temps de réponse ≤ 5hTaux de livraison dans les délais ≥ 57%

Attributs
plasticMatériel
OEM, ODM, OBMSupport personnalisé
3 ansGarantie
West Bengal, IndiaPoint d'origine
90mm ,60mm ,35mm ,150mmTaille
Petri dishNuméro de Type
Marque nom:Eleos Care
Classification:Petri Dish
Color:Transparent
Caractéristiques du produit
Matériel
plastic
Support personnalisé
OEM, ODM, OBM
Garantie
3 ans
Point d'origine
West Bengal, India
Taille
90mm ,60mm ,35mm ,150mm
Numéro de Type
Petri dish
Marque nom
Eleos Care
Classification
Petri Dish
Color
Transparent
Emballage et livraison
vente Unités
Article unique
unique poids brut
2.000 kg
Délai de préparation de la commande
Description des produits par le fournisseur
500 - 4 999 boîte
9,23 €
5 000 - 9 999 boîte
8,41 €
>= 10 000 boîte
7,35 €
Protection des commandes Alibaba.com
Paiements sécurisés
Chaque paiement que vous effectuez sur Alibaba.com est sécurisé par un cryptage SSL strict et des protocoles de protection des données PCI DSS.
Protection de remboursement
Demandez un remboursement si votre commande n'est pas expédiée, est introuvable ou arrive avec des problèmes liés au produit









